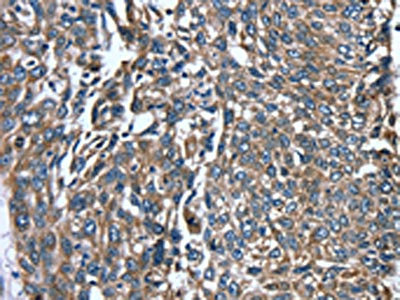

PTRH2 Antibody
-
中文名稱:PTRH2兔多克隆抗體
-
貨號(hào):CSB-PA698004
-
規(guī)格:¥1100
-
圖片:
-
The image on the left is immunohistochemistry of paraffin-embedded Human ovarian cancer tissue using CSB-PA698004(PTRH2 Antibody) at dilution 1/20, on the right is treated with fusion protein. (Original magnification: ×200)
-
The image on the left is immunohistochemistry of paraffin-embedded Human lung cancer tissue using CSB-PA698004(PTRH2 Antibody) at dilution 1/20, on the right is treated with fusion protein. (Original magnification: ×200)
-
Gel: 12%SDS-PAGE, Lysate: 40 μg, Lane 1-5: K562 cells, hepg2 cells, 231 cells, Jurkat cells, Raji cells, Primary antibody: CSB-PA698004(PTRH2 Antibody) at dilution 1/250, Secondary antibody: Goat anti rabbit IgG at 1/8000 dilution, Exposure time: 20 seconds
-
-
其他:
產(chǎn)品詳情
-
Uniprot No.:
-
基因名:PTRH2
-
別名:Bcl 2 inhibitor of transcription 1 antibody; Bcl-2 inhibitor of transcription 1 antibody; BIT 1 antibody; BIT1 antibody; CGI 147 antibody; CGI147 antibody; mitochondrial antibody; Peptidyl tRNA hydrolase 2 mitochondrial antibody; Peptidyl-tRNA hydrolase 2 antibody; PTH 2 antibody; PTH2 antibody; PTH2_HUMAN antibody; PTRH 2 antibody; PTRH2 antibody
-
宿主:Rabbit
-
反應(yīng)種屬:Human,Mouse
-
免疫原:Fusion protein of Human PTRH2
-
免疫原種屬:Homo sapiens (Human)
-
標(biāo)記方式:Non-conjugated
-
抗體亞型:IgG
-
純化方式:Antigen affinity purification
-
濃度:It differs from different batches. Please contact us to confirm it.
-
保存緩沖液:-20°C, pH7.4 PBS, 0.05% NaN3, 40% Glycerol
-
產(chǎn)品提供形式:Liquid
-
應(yīng)用范圍:ELISA,WB,IHC
-
推薦稀釋比:
Application Recommended Dilution ELISA 1:2000-1:5000 WB 1:500-1:2000 IHC 1:10-1:50 -
Protocols:
-
儲(chǔ)存條件:Upon receipt, store at -20°C or -80°C. Avoid repeated freeze.
-
貨期:Basically, we can dispatch the products out in 1-3 working days after receiving your orders. Delivery time maybe differs from different purchasing way or location, please kindly consult your local distributors for specific delivery time.
-
用途:For Research Use Only. Not for use in diagnostic or therapeutic procedures.
相關(guān)產(chǎn)品
靶點(diǎn)詳情
-
功能:The natural substrate for this enzyme may be peptidyl-tRNAs which drop off the ribosome during protein synthesis.; Promotes caspase-independent apoptosis by regulating the function of two transcriptional regulators, AES and TLE1.
-
基因功能參考文獻(xiàn):
- studies indicate Bit1 is an inhibitor of EMT and metastasis in lung cancer and hence can serve as a molecular target in curbing lung cancer aggressiveness PMID: 27655370
- These collective findings indicate that loss of Bit1 expression contributes to the acquisition of malignant phenotype of human lung epithelial cells via Erk activation-induced suppression of E-cadherin expression. PMID: 29170133
- This study reports on five infantile-onset multisystem neurologic, endocrine, and pancreatic disease (IMNEPD) patients with a different homozygous PTRH2 mutation, broaden the phenotypic spectrum of the disease and differentiate common symptoms and interindividual variability in IMNEPD associated with a unique mutation. PMID: 27129381
- Homozygous mutation in PTRH2 gene causes progressive sensorineural deafness and peripheral neuropathy in three sisters from a consanguineous family. PMID: 28328138
- Bcl-2 expression patterns in various differentiated esophageal squamous cell carcinoma were higher than those in corresponding normal esophageal tissues with no statistical differences ( p > 0.05). Importantly, Bit1 expression was positively correlated with both matrix metalloproteinase 2 and Bcl-2 expression in esophageal squamous cell carcinoma and esophageal adenocarcinoma tissues ( p < 0.05). PMID: 28488526
- Our data establishes a PTRH2 mutation as a novel driver of congenital muscle degeneration and identifies a potential novel target to treat muscle myopathies. PMID: 28175314
- Bit1 may be an important regulator in cell growth, apoptosis, migration and invasion of esophageal squamous cell carcinoma via targeting FAK-paxillin pathway. PMID: 26956728
- these findings suggest a tumor suppressive role of the caspase-independent anoikis effector Bit1 in lung cancer. PMID: 25003198
- Reduction of the Bit1 level in cytosol, regulated by E2 binding to ESR1, was mainly mediated through PI3K/AKT pathways. PMID: 25211327
- Bit1 plays pivotal roles in the development and progression of ESCC, and its biological functions in ESCC may be closely associated with AIF and Bcl-2 levels. PMID: 23955799
- TLE1 inhibits the Bit1 anoikis pathway by reducing the formation of the proapoptotic Bit1-AES complex in part through sequestration of AES in the nucleus. PMID: 22952044
- Bit1 may be a useful pathological marker and a prognostic marker for serous papillary adenocarcinomas outcome. PMID: 23259782
- Data indicate that the cell death domain (CDD) to the N-terminal 62 amino acids of Bit1 was more potent in killing cells than the full-length Bit1 protein when equivalent amounts of cDNA were transfected. PMID: 23248118
- downregulation of Bit1 conferred cancer cells with enhanced anoikis resistance, adhesive and migratory properties in vitro PMID: 21886829
- Bit-1 mediates integrin-dependent cell survival through activation of the NFkappaB pathway PMID: 21383007
- Results identify Bit1, a mitochondrial protein released into the cytoplasm during apoptosis that forms a complex with AES, a small Groucho/transducin-like enhancer of split (TLE) protein PMID: 15006356
- Reduced expression of the proapoptotic proteins Bit1 or overexpression of Bcl-2 improved myoblast transplantation survival. PMID: 17511679
- the PKD serine/threonine kinase is one of the signaling molecules through which integrin-mediated cell attachment controls Bit1 activity and anoikis PMID: 18703509
- TAp63gamma could induce apoptosis in human esophageal squamous cancer EC9706 cells, through at least releasing AIF and Bit1 from mitochindria into cytosol and nucleus, where apoptotic cascade takes place. PMID: 19578750
顯示更多
收起更多
-
相關(guān)疾病:Neurologic, endocrine, and pancreatic disease, multisystem, infantile-onset (IMNEPD)
-
亞細(xì)胞定位:Mitochondrion.
-
蛋白家族:PTH2 family
-
數(shù)據(jù)庫鏈接:
Most popular with customers
-
-
YWHAB Recombinant Monoclonal Antibody
Applications: ELISA, WB, IHC, IF, FC
Species Reactivity: Human, Mouse, Rat
-
-
-
-
-
-